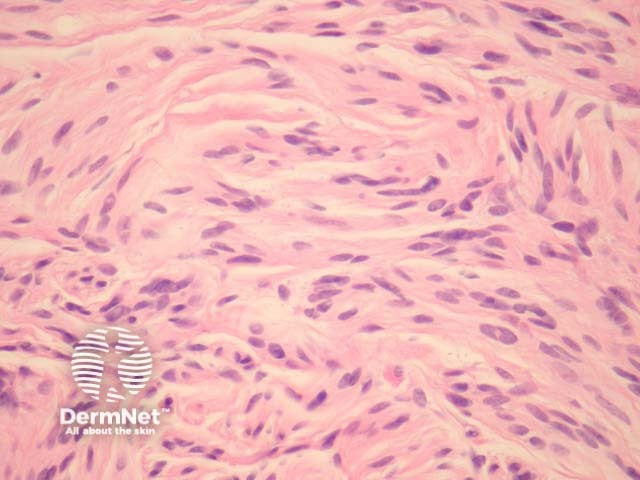
Figure 3

Main menu
Common skin conditions
NEWS
Join DermNet PRO
Read more
Quick links
Lesions (benign) Diagnosis and testing
Author: Assoc Prof Patrick Emanuel, Dermatopathologist, Auckland, New Zealand, 2013.
Introduction Histology Special studies Differential diagnoses
Palisaded and encapsulated neuroma is otherwise known as a solitary circumscribed neuroma. These lesions are typically small dermal nodules that occur on the face.
Palisaded and encapsulated neuroma is a circumscribed dermal tumour underlying an uninterrupted or attenuated epidermis (figure 1). A split between the tumour and the surrounding dermis is often seen (figures 1, 2).
The tumour is composed of a loose matrix and fascicles of spindled cells, which resemble schwannoma (figure 3).

Figure 1

Figure 2
Figure 3
None are generally needed. The lesion is S100 positive. The surrounding capsule exhibits EMA positivity. Axons course through the lesion and can be demonstrated with neurofilament.
Schwannoma – Its relationship with schwannoma has been questioned. Schwannomas display a varied cell density (Antoni A and B areas) and lack axons which are thought to course through palisaded and encapsulated neuroma.
Neurofibroma – These are typically non-encapsulated (with the exception of plexiform neurofibroma).